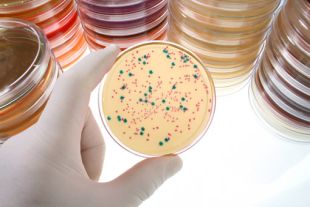

Anche Livorno aderisce alla Giornata illuminando, nella serata di sabato prossimo, il Gazebo della Terrazza Mascagni di colore viola.
16maggio 2018 da Comune Livorno
Il 19 maggio si celebrerà il World IBD Day – Giornata Mondiale delle malattie infiammatorie croniche dell’intestino (MICI) – e i monumenti di oltre 50 città italiane, come quelli di altri 50 paesi nel mondo, saranno illuminati di viola (colore simbolo di queste patologie) per sensibilizzare e informare l’opinione pubblica sulla condizione delle persone che convivono con la malattia di Crohn e la colite ulcerosa.
Il 19 maggio si celebrerà il World IBD Day – Giornata Mondiale delle malattie infiammatorie croniche dell’intestino (MICI) – e i monumenti di oltre 50 città italiane, come quelli di altri 50 paesi nel mondo, saranno illuminati di viola (colore simbolo di queste patologie) per sensibilizzare e informare l’opinione pubblica sulla condizione delle persone che convivono con la malattia di Crohn e la colite ulcerosa.
Cinque milioni di persone nel mondo e circa 200.000 in Italia soffrono di una malattia infiammatoria cronica dell’intestino e i numeri sono destinati a crescere nei prossimi anni – dichiara l’associazione Amici Onlus, che da oltre trent’anni è impegnata nella difesa e nella rappresentanza delle persone con questa patologia invalidante. A tale proposito ricorda la campagna social #VorreCheIlMioMedicoSapesseChe, recentemente lanciata, per dare voce ai malati che spesso, per paura o per vergogna, non si rendono conto che la cosa più sbagliata sia proprio quella di non chiedere nulla.


